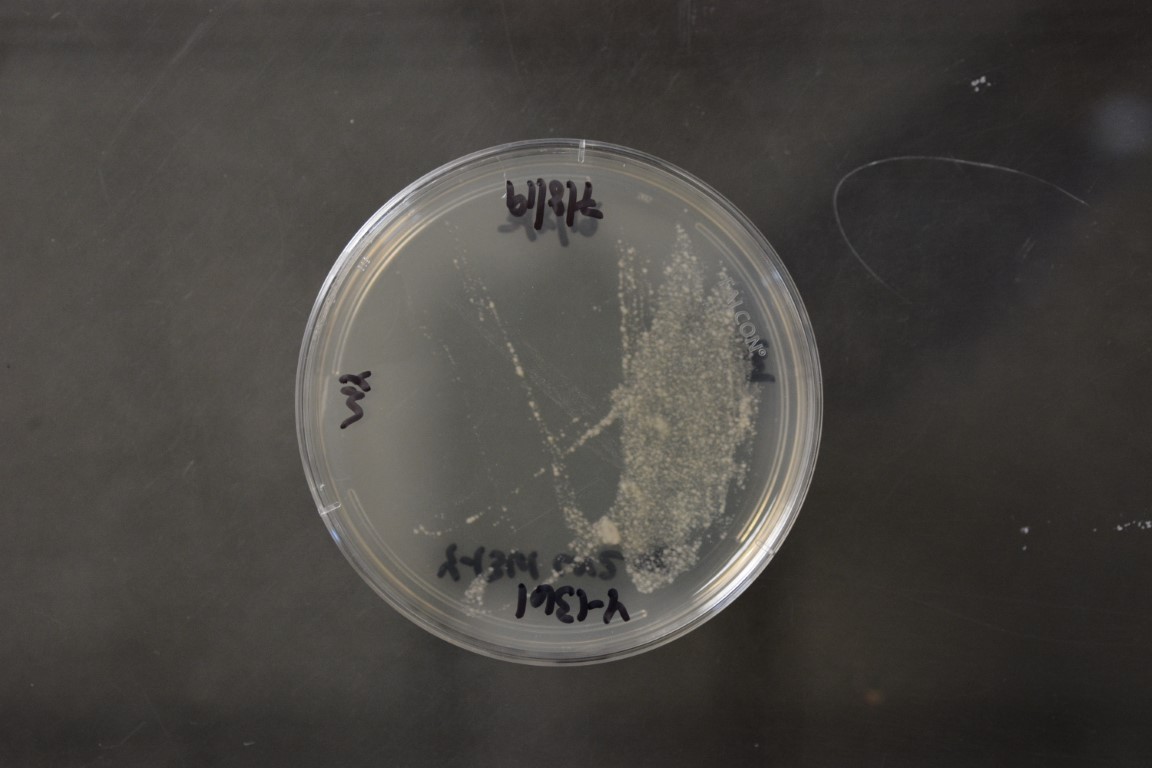

Schizosaccharomyces japonicus
NRRL Y-1361(Type Strain)
Accession numbers in other collections:ATCC 10660=CBS 354=CCRC 21523=CCY 44-5-1=DBVPG 6274=IFO 1609=JCM 8264=Yamada CS-10
Source:CBS,Delft,The Netherlands
Isolated from(substrate):WN,strawberry wine
Substrate location:Japan
Genetic info:ROBNETT RNA,GB L11113,L19680,L20467;ROBNETT PCR#670.GenBank:D1/D2(U94943)(AB243296),RNA subunit of RNAse(GU470884).
Growth media:Yeast Extract-Malt Extract-Peptone-Glucose(YM for yeasts)(number 6)
Optimum growth temperature:25C
Strain images:
NRRL_Y-1361_6.JPG